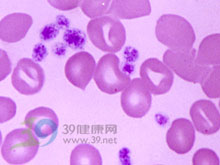
血管性血友病

血管性血友病
血管性血友病病因
 X染色體
X染色體VWD在臨床上存在著遺傳變異型。根據因子ⅧR:Ag的生化特點及其功能將VWD分成數型。I型多見,表現為因子ⅧR∶Ag數量缺乏,各種聚合物的含量均減少,因子Ⅷ所有活性均降低,但結構正常。I型中分為常染色體隱性或顯性遺傳兩種,前者較少見,臨床表現極嚴重。血漿中ⅧR∶Ag消失或少於0.1%,也不能因注射DDAVP而提高。Ⅱ型:其ⅧR∶Ag的量正常,但因子ⅧR∶Ag聚合物的結構異常。Ⅷ∶C量正常或略低,呈常染色體顯性遺傳。這類患者缺乏高分子量及中分子量的聚合物。Ⅱ型中又分若干亞型。
症狀
 關節畸形
關節畸形本病的發病率較血友病為高,是遺傳性出血性疾病中較常見的一種,臨床表現為出血傾向,出血有鼻衄、齒齦出血、胃腸道出血,拔牙或外科手術沒有嚴重出血,婦女月經量多,產後常有大量出血。常發生於兒童期,隨年齡的增長,出血的嚴重程度可逐漸減輕。常染色體隱性遺傳(I型)的病例出血嚴重,可危及生命。關節出血多在外傷後發生,不遺留永久性關節畸形。
診斷
一、病史及症狀
⑴病史提問:注意發病的年齡、出血的誘因、出血程度及部位,出血的程度和頻度是否隨年齡的增長而趨於減輕。女性是否有月經過多或產後出血過多史。
⑵臨床症狀:鼻衄、牙齦出血、皮膚瘀斑常見,偶有血尿、胃腸道出血及顱內出血,關節出血罕見。外傷或手術後出血嚴重,且不易止血。女性月經過多。
二、體檢發現
皮膚黏膜可見瘀斑,創傷部位滲血,如有關節出血可見關節腫脹,壓痛,活動障礙。
三、實驗室檢查
檢查
 紅細胞
紅細胞2.出血時間延長或阿斯匹林耐量試驗陽性。
3.活化的部分凝血活酶時間延長或正常。
4.血小板粘附率降低或正常(64.2%±8.3%)。
5.因子VIII凝血活性測定降低或正常。
6.vWF抗原(vWF:Ag)減低或正常。
7.血管脆性試驗陽性。
治療
1.禁用阿司匹林、保泰松、消炎痛、潘生丁及低分子右鏇醣酐、前列腺素E1等可影響止血凝血機能的藥物,以防加重出血。
 避孕藥
避孕藥3.纖溶抑制物如6-氨基己酸(EACA)每日口服4~5g,每6小時一次,可減輕黏膜出血,對月經過多也有效。本病中局部纖維蛋白溶解是許多組織尤其是黏膜出血的原因之一。
4.輸新鮮血補充缺乏的因子Ⅷ,為有效的止血措施。輸血後Ⅷ∶C在12~24小時內逐漸升高,使出血傾向得到控制,但血小板瑞斯托黴素聚集作用及ⅧR∶Ag在輸血完畢後即迅速降低,所以輸血對三者的效應不相一致。嚴重病例應補充冷沉澱製劑,劑量為30~50u/kg,每24~48小時注射一次,有良好的療效。因子Ⅷ濃縮製劑中缺少與VW因子活性有關的高分子聚合物,所以不能糾正出血缺陷,故不作為首選藥物。
5.DDAVP(1-去氨基-8-D精氨酸加壓素)是人工合成的抗利尿激素的同類物,經靜脈注射一定劑量後,血漿因子Ⅷ活性可明顯增高,用於治療輕症或中、重度病例,但對嚴重病例無效。慢速靜脈注射給藥劑量為0.3~0.5μg/kg,溶於20~30ml生理鹽水,因可激活纖溶系統,需與止血環酸,EACA合用。可使因子Ⅷ(Ⅷ∶C及ⅧR∶Ag)的水平提高2~3倍,注射後30~60分鐘達到高峰,可以制止局部鼻出血及拔牙等小手術出血。為維持因子Ⅷ濃度最初2~4天內每8~12小時1次,經鼻腔內滴入的劑量為0.25ml(每ml含1300μg),每日2次。副作用有暫時性面部潮紅及水滯留。
6.手術本病原則上應避免手術,必需手術時應在術前及術後輸注新鮮血,血漿或因子Ⅷ濃縮物,以補充缺乏的因子。
鑑別
 淋巴增生
淋巴增生(一)血小板型血管性血友病 本病為一類血小板功能異常,血小板與血漿內的VW因子親和性增加,因而使血漿內的VW因子缺乏,引起類似血管性血友病的表現,需加以區別。本病常合併有血小板減少。患者血小板對低濃度的瑞斯托黴素聚集反應增強,可有自發性血小板聚集。如加入正常人的血小板則聚集功能恢復正常。
(二)獲得性血管性血友病 見於系統性紅斑狼瘡、淋巴增生性疾病、血管增生性疾病及腎上腺腫瘤。臨床表現除原發病症狀外,出血傾向與遺傳性VWD相似,VW因子也有明顯減少。在少數病例中可找到抗VW因子的抗體。本病尚需與輕型血友病甲區別。
(三)血小板功能障礙性疾病需與輕型的血管性血友病相區別。輕型VWD經輸入新鮮血漿或冷沉澱物,可使出血好轉,出血時間及因子Ⅷ的有關活性恢復正常,而血小板功能障礙性疾病則療效不明顯。
預防
本病主要是由於遺傳所致,只有基因治療才能根治,目前只能採取預防出血及對症治療。出血的程度和頻度隨年齡的增長而趨於減輕。
併發症
 牙齦出血
牙齦出血3.關節出血罕見。
4.外傷或手術後出血嚴重,且不易止血。
5.女性月經過多
